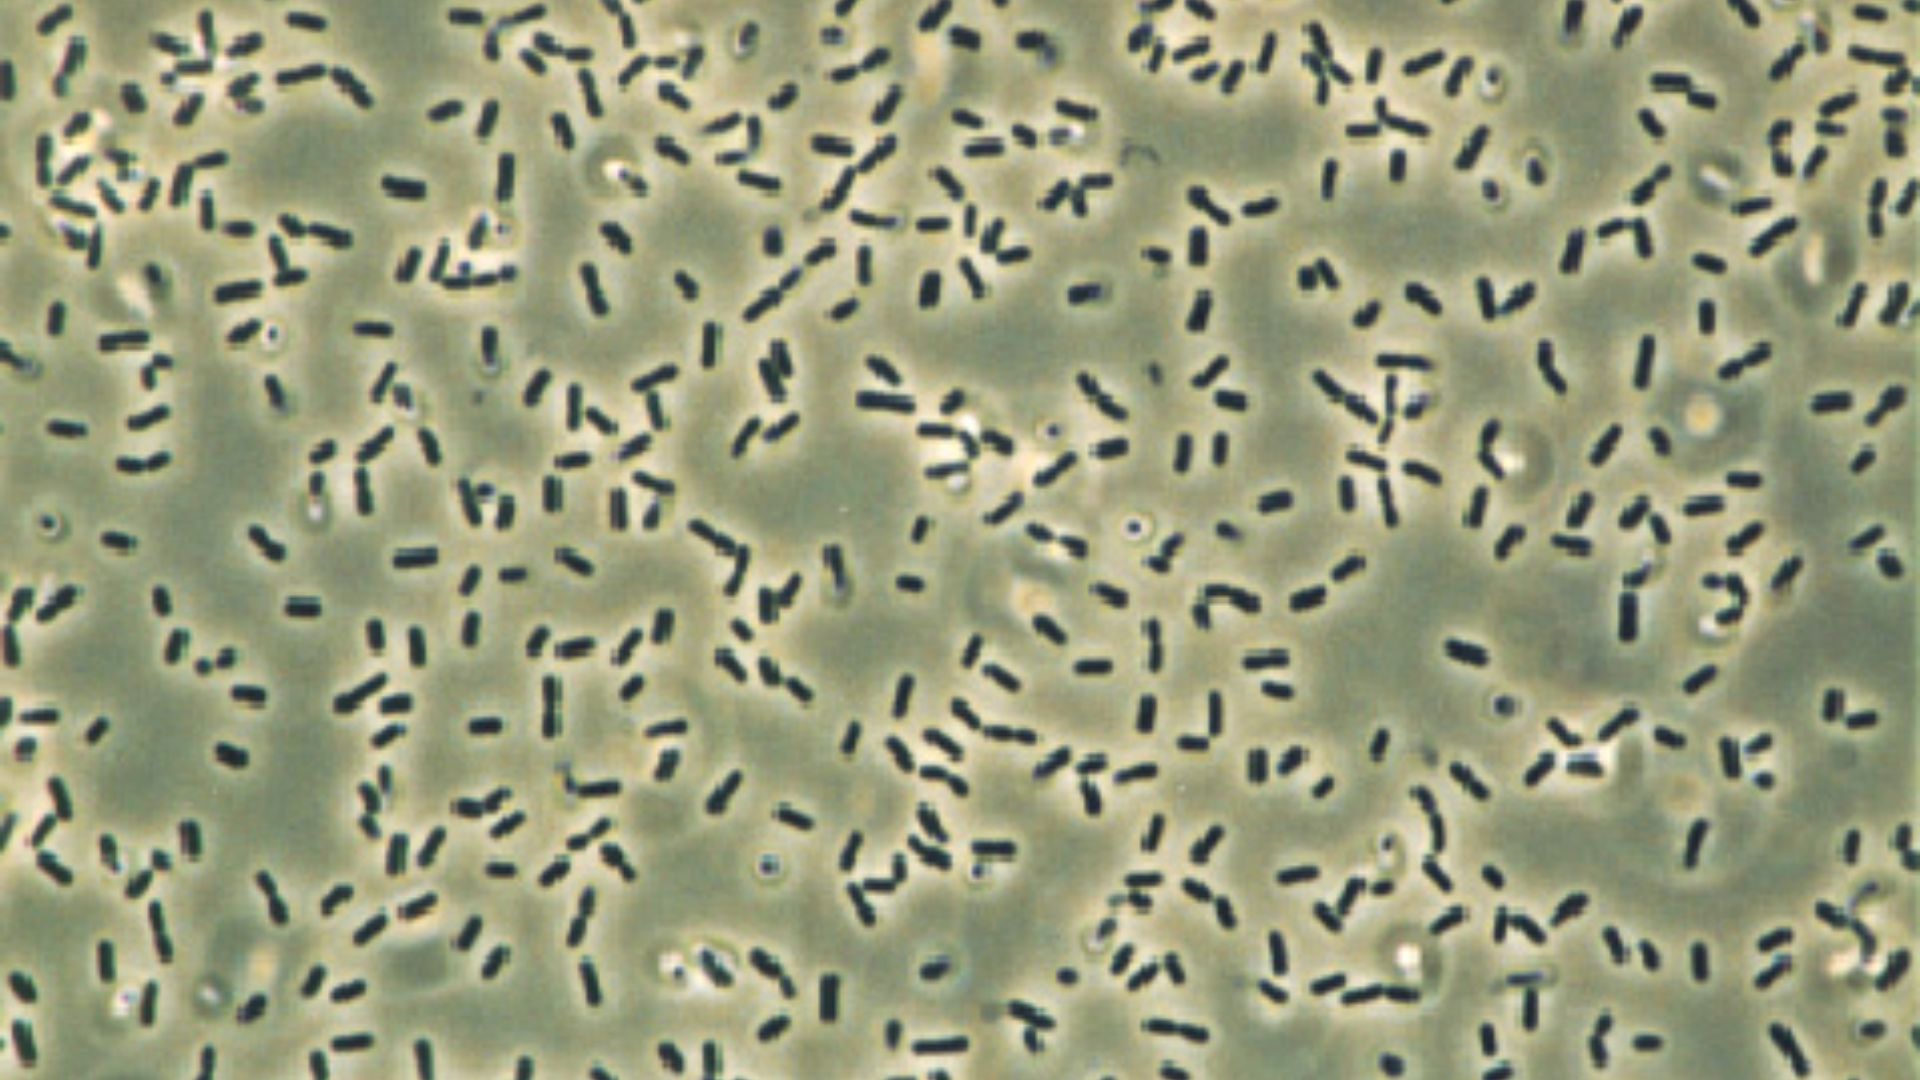
File:Bacillus subtilis (2).jpg
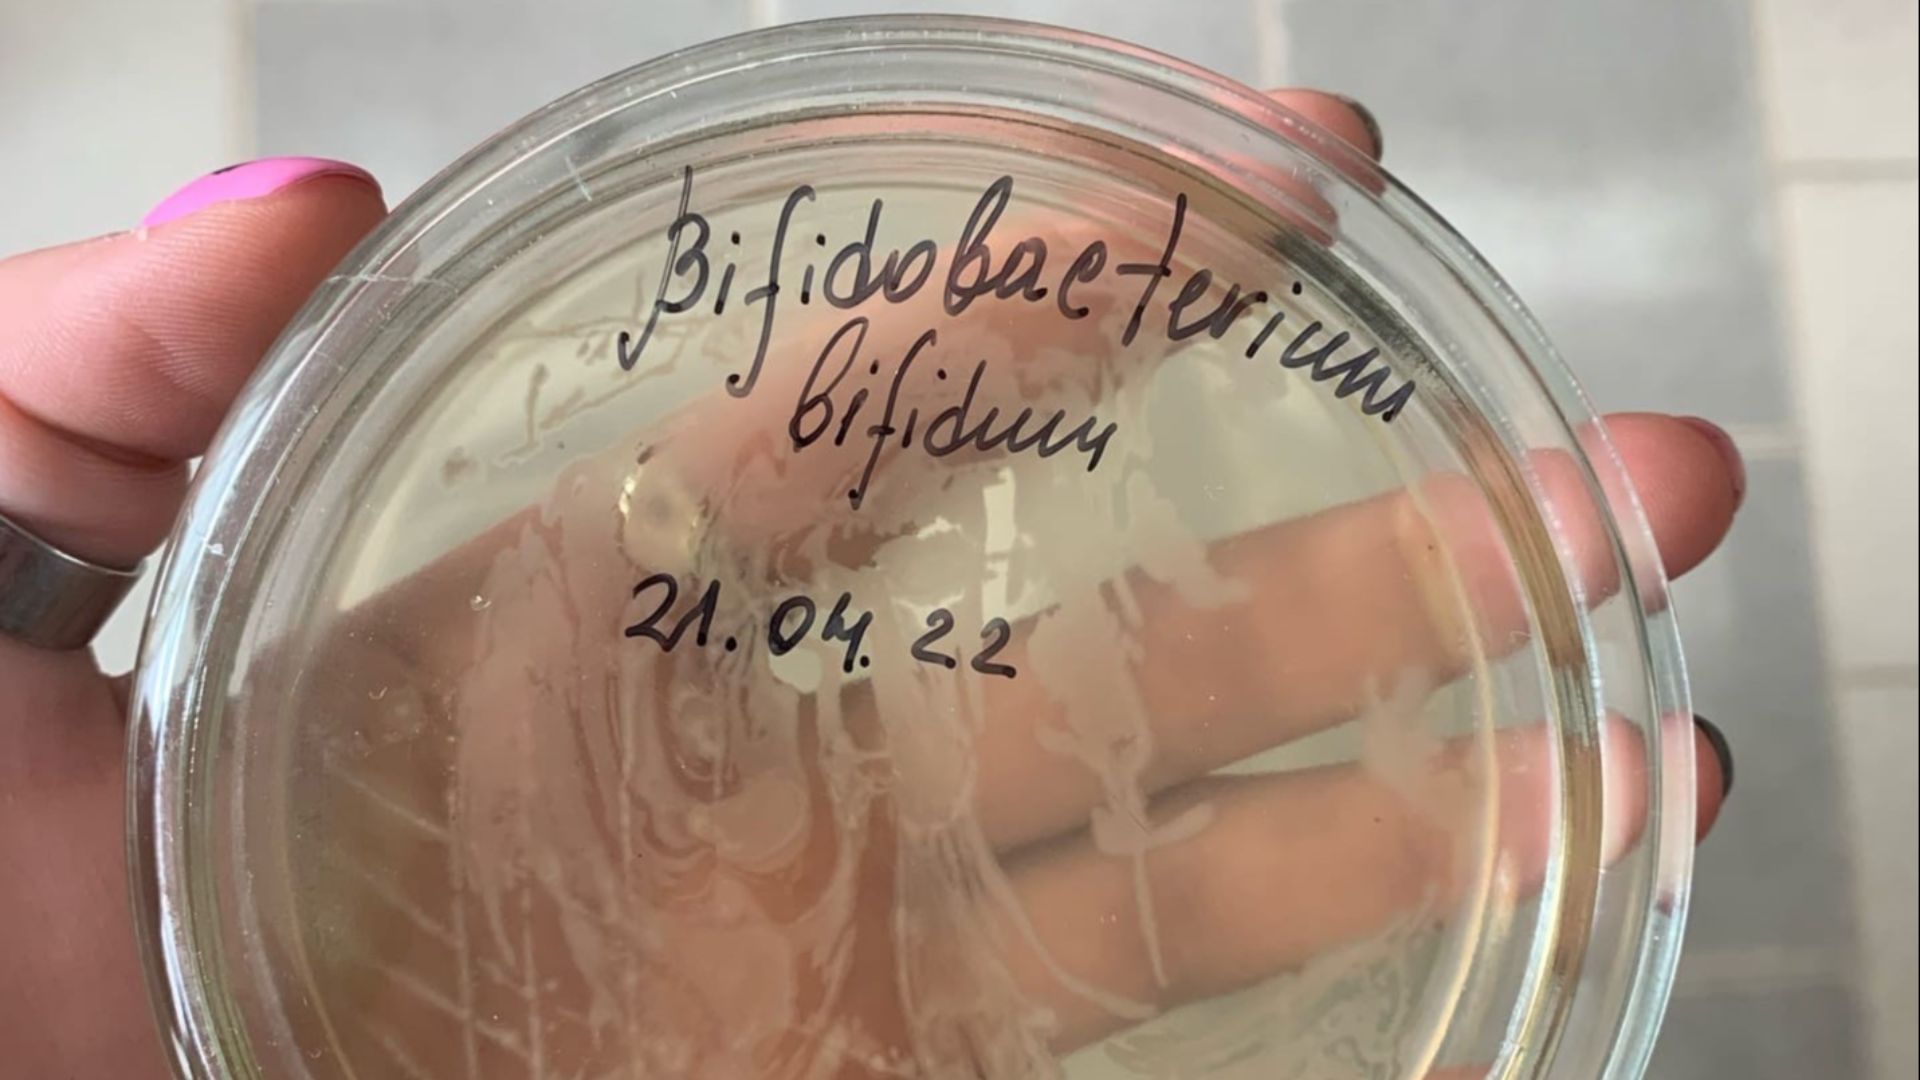
File:Bifidobacterium bifidum, рост в чашках.jpg

Some Heal, Some Hype
We’ve all been told to “trust our gut,” but this is easier said than done as far as probiotics are concerned. Somewhere between kefir and kombucha, we’ve all wondered: which of these microscopic freeloaders are actually doing something? The reality is, not every probiotic earns its keep. Here are ten strains that are rockstars and ten that shouldn’t even be on the lineup.
1. Lactobacillus rhamnosus GG
After decades of research and multiple clinical trials, this strain still manages to uphold its reputation. It helps with antibiotic-related diarrhea and the upset stomach travelers develop after a suspicious sandwich at the Lisbon airport. You can find it in Culturelle, among other supplements, and it’s one of the few that reliably survives stomach acid to reach the intestines alive.
 National Institute of Allergy and Infectious Diseases on Unsplash
National Institute of Allergy and Infectious Diseases on Unsplash
2. Bifidobacterium longum
This strain helps calm inflammation, support your immune system, and even lift your mood, proving that the gut-mind connection is real. You’ll often see it in fermented dairy and “mood” probiotic blends.
3. Lactobacillus plantarum
Found naturally in kimchi, sauerkraut, and even sourdough starter, this strain is the one driving the fermentation process. It’s known to soothe IBS symptoms and reinforce the gut lining, helping you avoid that mysterious mid-afternoon bloat.
4. Saccharomyces boulardii
Although technically a yeast, not a bacterium, it deserves honorary probiotic status. It works wonders when antibiotics wipe out your gut flora and also helps prevent that infamous “Montezuma’s revenge” while traveling.
5. Bifidobacterium bifidum
This is one of the first strains to colonize your intestines after birth. Later in life, it reliably helps digest dairy, supports your immune system, and can make you less susceptible to colds.
6. Lactobacillus casei
Often found working alongside L. acidophilus and B. bifidum, this strain improves lactose digestion and helps ease constipation. It may help regulate the immune response, which sounds vague until you realize it means a lower chance of autoimmunity and allergic reactions to things like pollen or peanuts.
 National Institute of Allergy and Infectious Diseases on Unsplash
National Institute of Allergy and Infectious Diseases on Unsplash
7. Bifidobacterium breve
This strain is especially beneficial for babies and assists in breaking down sugars in breast milk as well as reducing their eczema risk. That said, adults benefit too, especially when it comes to bloating and IBS.
 National Institute of Allergy and Infectious Diseases on Unsplash
National Institute of Allergy and Infectious Diseases on Unsplash
8. Lactobacillus reuteri
This somewhat scandalously was isolated from human breast milk, but it’s been proven to help reduce colic in infants, as well as gum inflammation in adults. It’s also shown some promise in helping balance gut microbiota, especially by reducing inflammation and supporting healthy gut barrier function.
 National Institute of Allergy and Infectious Diseases on Unsplash
National Institute of Allergy and Infectious Diseases on Unsplash
9. Streptococcus thermophilus
This is the friendly cousin of the strep bacteria—yes, really. It’s used in yogurt production because it helps digest lactose and may also protect the gut lining. It helps make dairy a little more forgiving for those of us who like cheese but suffer for it later.
10. Lactobacillus acidophilus
This classic strain is the one that made probiotics a household name. It’s everywhere, from yogurt to pills to fermented milk drinks. It assists with lactose digestion, supports vaginal health, and overall bacterial balance.
Now, for the strains that sound fancy but contribute little and coast on marketing buzzwords.
 National Institute of Allergy and Infectious Diseases on Unsplash
National Institute of Allergy and Infectious Diseases on Unsplash
1. Lactobacillus bulgaricus
While this strain is crucial for yogurt-making, it’s pretty much useless as a probiotic. The moment it hits your stomach acid, it essentially dies. Your gut has likely never even seen it.
 National Institute of Allergy and Infectious Diseases on Unsplash
National Institute of Allergy and Infectious Diseases on Unsplash
2. Bacillus coagulans
While certain strains might be beneficial, others accomplish nothing. It’s spore-forming, which means it can create a dormant shell to protect the bacteria inside. However, that toughness means it sometimes doesn’t integrate well into the gut.
 Dr. William A. Clark on Wikimedia
Dr. William A. Clark on Wikimedia
3. Enterococcus faecium
Some strains behave like helpful tenants, quietly supporting digestion, while others are the kind that overstay their welcome. Technically, it’s already a natural resident of our guts, but even the harmless strains have been linked to antibiotic resistance.
 Photo Credit: Janice Haney Carr
Content Providers(s): CDC/ Janice Carr on Wikimedia
Photo Credit: Janice Haney Carr
Content Providers(s): CDC/ Janice Carr on Wikimedia
4. Lactobacillus gasseri
Although touted for its ability to reduce belly fat, the supporting studies are shaky and inconsistent. The main issue is that most of the positive effects vanish the moment you stop supplementing, which makes it rather useless in the long term.
 National Institute of Allergy and Infectious Diseases on Unsplash
National Institute of Allergy and Infectious Diseases on Unsplash
5. Escherichia coli Nissle 1917
Some studies say it helps with ulcerative colitis; others say it’s not much better than a placebo. The awkward association with E. coli also makes it unlikely that this will ever become a popular supplement.
6. Lactobacillus fermentum
This strain appears in a lot of supplements and fermented foods, but the data’s underwhelming. Sure, it ferments things, but that innate ability doesn’t seem to improve digestion or immunity in any measurable way.
7. Bacillus subtilis
This strain is found in soil and sometimes marketed as a hardy probiotic that can survive your stomach acid on the way to your intestines. While this may be true, the ability to make it past the stomach doesn’t equate to any other health benefits.
Kookaburra at German Wikipedia on Wikimedia
Kookaburra at German Wikipedia on Wikimedia
8. Lactobacillus helveticus
While this strain is popular in cheese-making, it doesn’t offer much benefit to your gut health. A few companies have tried to market it for stress relief, though evidence suggests it’s mostly placebo with better branding.
 National Institute of Allergy and Infectious Diseases on Unsplash
National Institute of Allergy and Infectious Diseases on Unsplash
9. Streptococcus salivarius
This bacteria naturally lives in your mouth, not your gut. And while it’s great for dental health, taking it for gut benefits makes about as much sense as using toothpaste for stomach pain.
10. Bifidobacterium animalis
This strain is often advertised on yogurt labels under the name of Bifidus regularis—a marketing name coined to drive home its purported benefits for gut health. Despite the great PR, it has minimal proven benefits aside from making yogurt more appealing in commercials.
 National Institute of Allergy and Infectious Diseases on Unsplash
National Institute of Allergy and Infectious Diseases on Unsplash
KEEP ON READING

20 Ways Perimenopause Changes Fitness and Appetite

20 Unhealthy Obsessions People Have

20 Gut-Friendly Fermented Foods For Everyday Meals